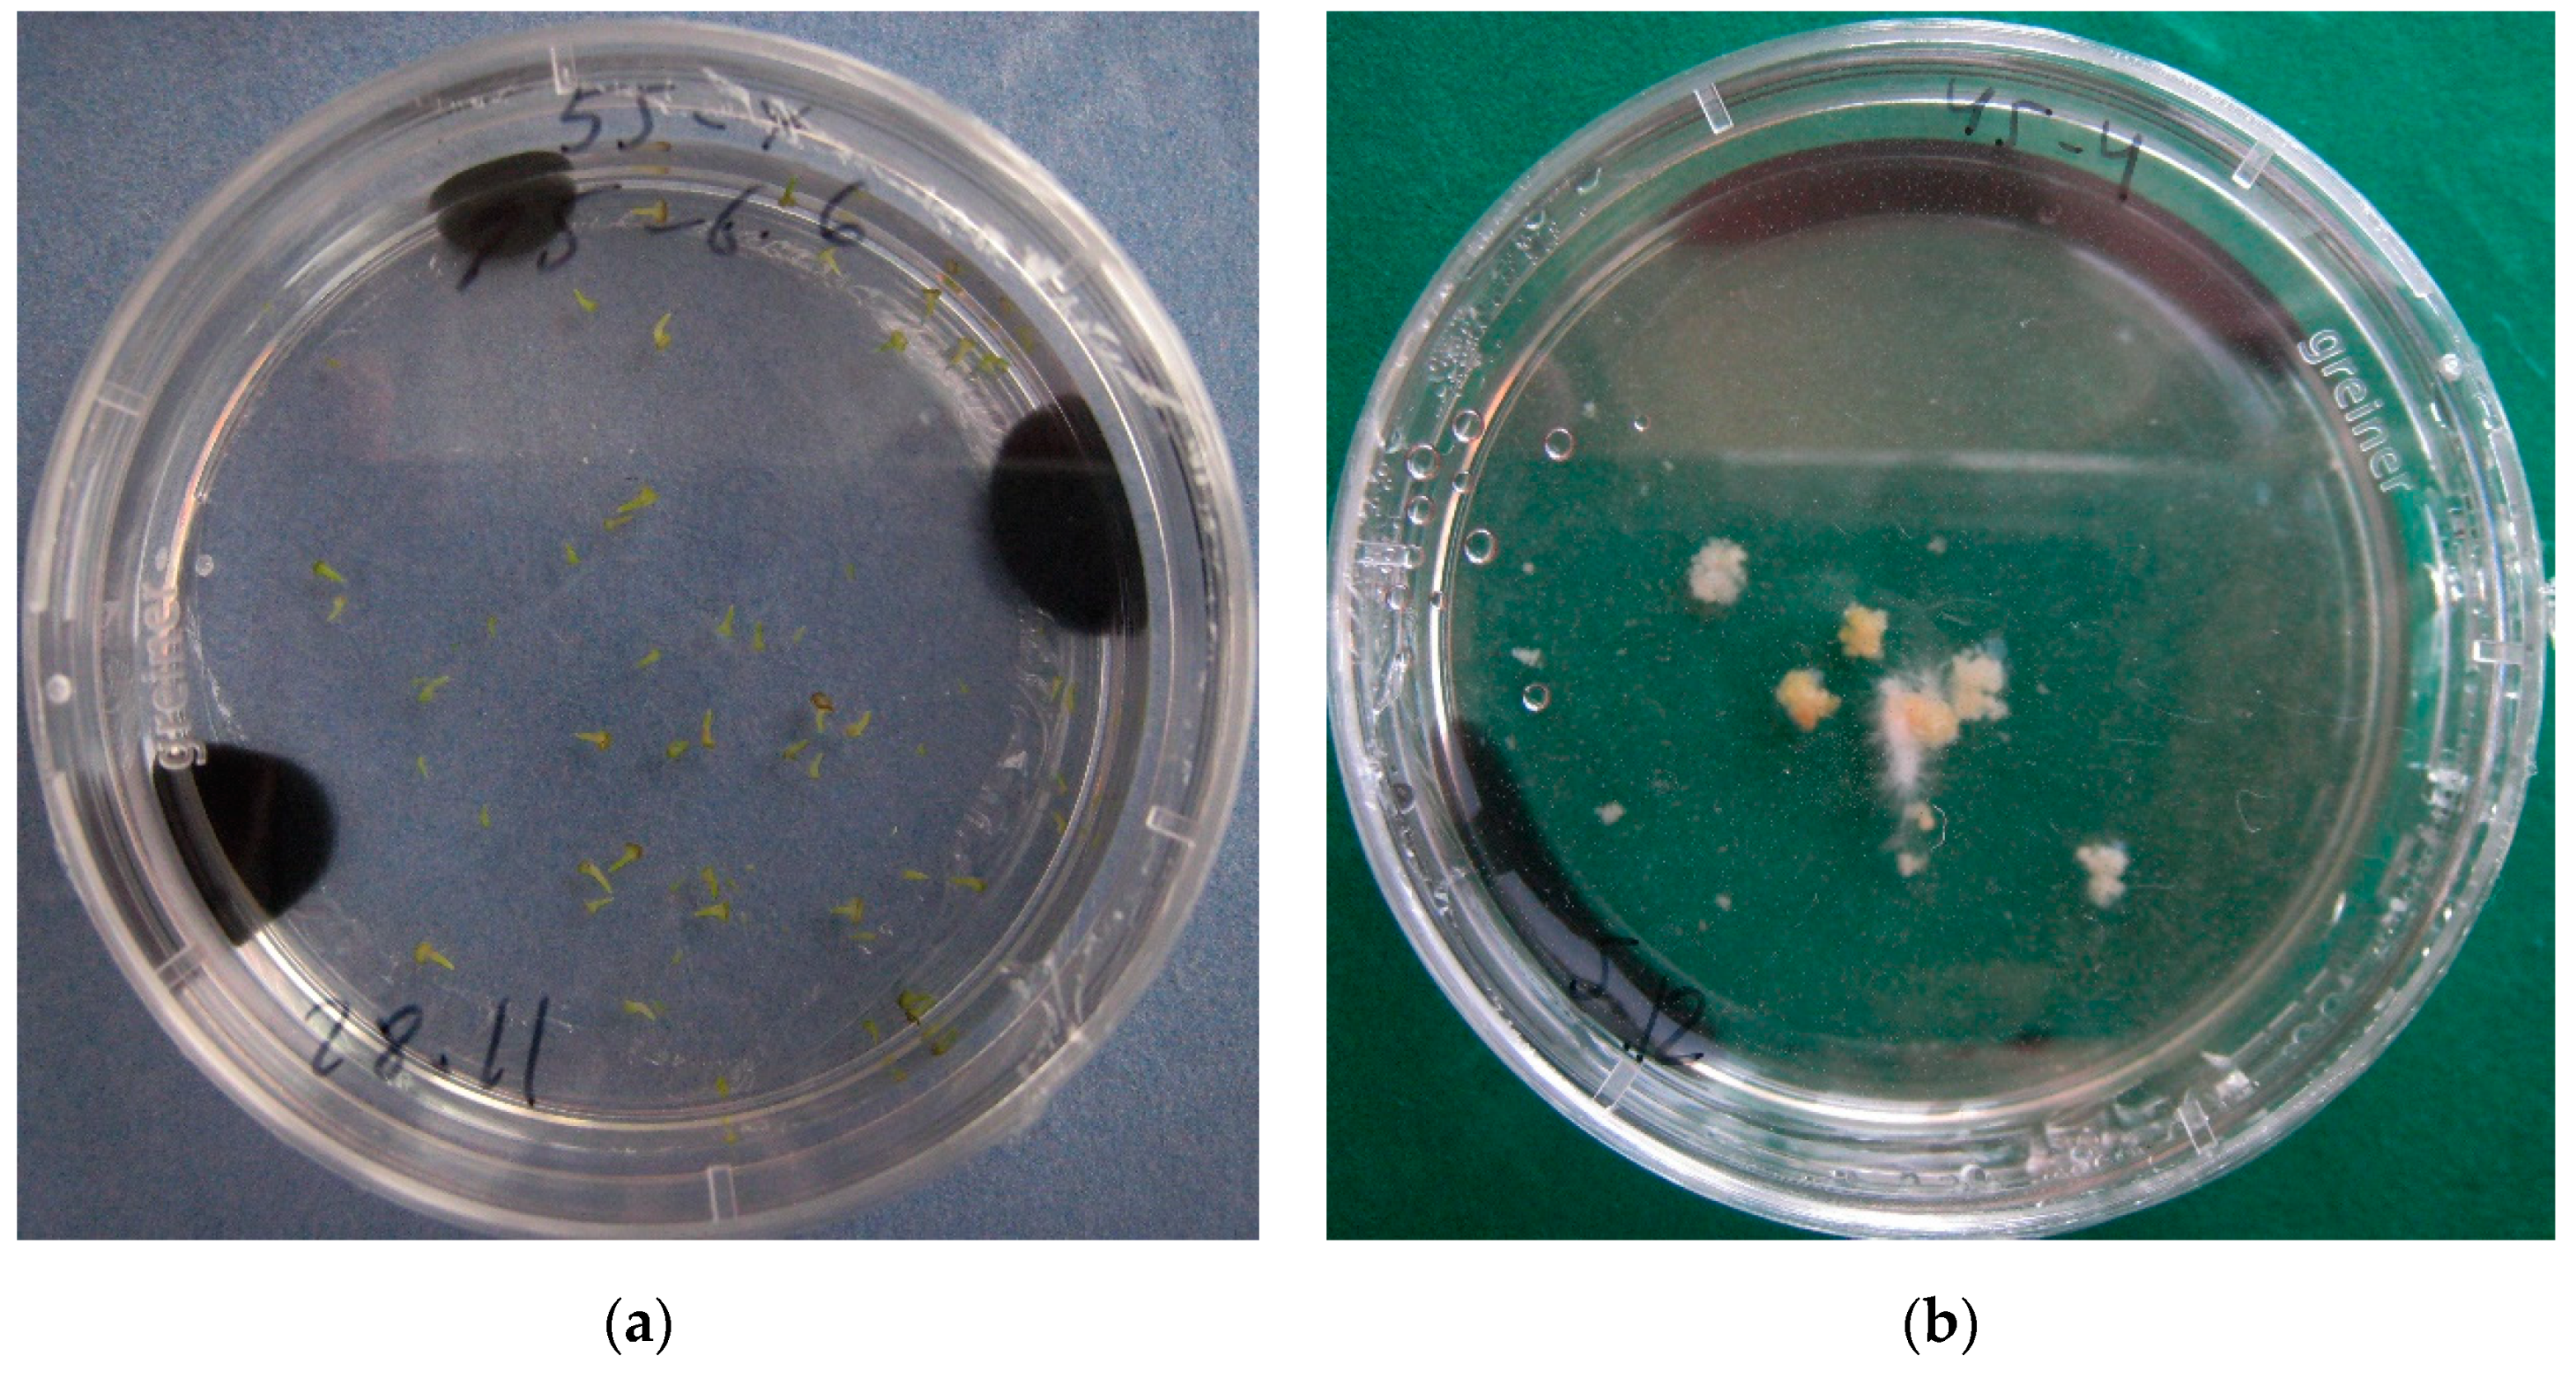

Effects of Genotype and Culture Conditions on Microspore Embryogenesis and Plant Regeneration in Brassica Rapa ssp. Rapa L.
Abstract
1. Introduction
2. Results
2.1. The Dependence of Embryogenesis in the Turnip Microspore Culture on the Genotype
2.2. Optimisation of Microspore Culture Parameters for Embryo Production
2.3. Embryogenesis in the Microspore Culture of a Turnip Variety with Microsporogenesis Disorders
- (a)
- small trilobed cells, which finally died;
- (b)
- cells which followed the original gametophytic route by dividing asymmetrically and producing generative and vegetative nuclei typical of pollen grains, non-embryogenic structures;
- (c)
- microspores that underwent a few divisions, with enlarged cells of variable sizes that finally became arrested; and
- (d)
- embryogenic structures that grew to globular, heart, torpedo, and cotyledonary stages.
2.4. A Study on Microspore Development in the In Vitro Culture
2.5. Production of Doubled Haploid (DH) Plantlets
2.6. Ploidy Level Determination
3. Discussion
4. Materials and Methods
4.1. Plant Material and Plants Growing Conditions
4.2. Microspore Culture
4.3. The Influence of Plant Genotype on the Induction of Embryogenesis in Microspore Culture
4.4. The Influence of the Medium pH and Activated Charcoal Addition on the Induction of Embryogenesis in Microspore Culture
4.5. Plant Regeneration
4.6. Plantlets Growing
4.7. Ploidy Level Determination
4.8. Statistical Analysis
Supplementary Materials
Author Contributions
Funding
Conflicts of Interest
References
- Lichter, R. Induction of haploid plants from isolated pollen of Brassica napus. Z. Pflanzenphysiol. 1982, 105, 427–434. [Google Scholar] [CrossRef]
- Guo, Y.D.; Pulli, S. High-frequency embryogenesis in Brassica campestris microspore culture. Plant Cell Tissue Organ Cult. 1996, 46, 219–225. [Google Scholar] [CrossRef]
- Seo, M.; Sohn, S.; Park, B.; Ko, H.; Jin, M. Efficiency of microspore embryogenesis in Brassica rapa using different genotypes and culture conditions. J. Plant Biotechnol. 2014, 41, 116–122. [Google Scholar] [CrossRef]
- Yuan, S.; Su, Y.; Liu, Y.; Fang, Z.; Yang, L.; Zhuang, M.; Zhang, Y.; Sun, P. Effects of pH, MES, arabinogalactan-proteins on microspore cultures in white cabbage. Plant Cell Tissue Organ. Cult. 2012, 110, 69–76. [Google Scholar] [CrossRef]
- Gu, H.H.; Hagberg, P.; Zhou, W.J. Cold pretreatment enhances microspore embryogenesis in oilseed rape (Brassica napus L.). Plant Growth Regul. 2004, 42, 137–143. [Google Scholar] [CrossRef]
- Zhang, Y.; Wang, A.; Liu, Y.; Feng, H. Improved production of doubled haploids in Brassica rapa through microspore culture. Plant Breed. 2012, 131, 164–169. [Google Scholar] [CrossRef]
- Prem, D.; Gupta, K.; Agnihotri, A. Effect of various exogenous and endogenous factors on microspore embryogenesis in Indian mustard (Brassica juncea [L.] Czern & Coss). Cell Dev. Biol. Plant. 2005, 41, 266–273. [Google Scholar] [CrossRef]
- Takahashi, Y.; Yokoi, S.; Takahata, Y. Effects of genotypes and culture conditions on microspore embryogenesis and plant regeneration in several subspecies of Brassica rapa L. Plant Biotechnol. Rep. 2012, 6, 297–304. [Google Scholar] [CrossRef]
- Dias, J.C. Effect of activated charcoal on Brassica oleracea microspore culture embryogenesis. Euphytica 1999, 108, 65–69. [Google Scholar] [CrossRef]
- Margale, E.; Chevre, A.M. Factors effecting embryo production from microspore culture of Brassica nigra (Koch). Crucif. Newsl. 1991, 14, 100–101. [Google Scholar]
- Prem, D.; Gupta, K.; Sarkar, G.; Agnihotri, A. Activated charcoal induced high frequency microspore embryogenesis and efficient doubled haploid production in Brassica juncea. Plant Cell Tissue Organ Cult. 2008, 93, 269–282. [Google Scholar] [CrossRef]
- Kott, L.S.; Beversdorf, W.D. Enhanced plant regeneration from microspore-derived embryos of Brassica napus by chilling, partial dessication and age selection. Plant Cell Tissue Organ Cult. 1990, 23, 187–192. [Google Scholar] [CrossRef]
- Huang, B.; Bird, S.; Kemble, R.; Miki, B.; Keller, W. Plant regeneration from microspore-derived embryos of Brassica napus: Effect of embryo age, culture temperature, osmotic pressure, and abscisic acid. Cell Dev. Biol. 1991, 27, 28–31. [Google Scholar] [CrossRef]
- Wakui, K.; Takahata, Y.; Kaizuma, N. Effect of abscisic acid and high osmoticum concentration on the induction of desiccation tolerance in microspore-derived embryos of Chinese cabbage (Brassica campestris L.). Breed Sci. 1994, 44, 29–34. [Google Scholar] [CrossRef]
- Zhang, G.Q.; Zhang, D.Q.; Tang, G.X.; He, Y.; Zhou, W.J. Plant development from microspore-derived embryos in oilseed rape as affected by chilling, desiccation and cotyledon excision. Biol. Plant. 2006, 50, 180–186. [Google Scholar] [CrossRef]
- Shumilina, D.V.; Shmykova, N.A.; Bondareva, L.L.; Suprunova, T.P. Effect of genotype and medium culture content on microspore-derived embryo formation in chinese cabbage (Brassica rapa ssp. chinensis) cv. Lastochka Biol. Bull. 2015, 42, 302–309. [Google Scholar] [CrossRef]
- Shmykova, N.A.; Shumilina, D.V.; Suprunova, T.P. Doubled haploid production in Brassica L. Seeds Vavilovskii Zhurnal Genetiki i Selektsii. Vavilov J. Genet. Breed. 2015, 19, 111–120. [Google Scholar] [CrossRef][Green Version]
- Supena, E.D.J. Innovations in Microspore Embryogenesis in Indonesian Hot Pepper (Capsicum Annuum L.) and Brassica Napus L. Ph.D. Thesis, Wageningen University, Wageningen, The Netherlands, 2004; p. 131. [Google Scholar]
- Domblides, E.A.; Kozar, E.V.; Shumilina, D.V.; Zayachkovskaya, T.V.; Akhramenko, V.A.; Soldatenko, A.V. Embryogenesis in culture of isolated microspore of broccoli. Veg. Crop. Russ. 2018, 1, 3–7. [Google Scholar] [CrossRef]
- Chuong, P.V.; Deslauriers, C.; Kott, L.S.; Beversdorf, W.D. Effects of donor genotype and bud sampling on microspore culture of Brassiccl napus. Can. J. Bot. 1988, 66, 1653–1657. [Google Scholar] [CrossRef]
- Gland, A.; Lichter, R.; Schweiger, H.G. Genetic and exogenous factors affecting embryogenesis in isolated microspore cultures of Brassica napus L. J. Plant Physiol. 1988, 132, 613–617. [Google Scholar] [CrossRef]
- Tuncer, B. Callus formation from isolated microspore culture in radish (Raphanus sativus L.). J. Anim. Plant Sci. 2017, 27, 277–282. [Google Scholar]
- Sato, S.; Katoh, N.; Iwai, S.; Hagimori, M. Effect of low temperature pretreatment of buds or inflorescence on isolated microspore culture in Brassica rapa (syn. B. campestris). Breed. Sci. 2002, 52, 23–26. [Google Scholar] [CrossRef]
- Osolnik, B.; Bohanes, B.; Jelaska, S. Stimulation of androgenesis in white cabbage (Brassica oleracea var. capitata) anthers by low temperature and anther dissection. Plant Cell Tissue Organ Cult. 1993, 32, 241–246. [Google Scholar] [CrossRef]
- Yadollani, A.; Abdollani, M.R.; Moieni, A. Effects of carbon source, polyethylene glycol and abscisic acid on secondary embryo induction and maturation in rapeseed (Brassica napus L.) microspore derived embryos. Acta Physiol. Plant. 2011, 33, 1905–1912. [Google Scholar] [CrossRef]
- Weber, S.; Unker, F.; Friedt, W. Improved doubled haploid production protocol for Brassica napus using microspore colchicines treatment in vitro and ploidy determination by flow cytometry. Plant Breed J. 2005, 124, 511–513. [Google Scholar] [CrossRef]
- Mohammadi, P.P.; Moieni, A.; Ebrahimi, A.; Javidfar, F. Doubled haploid plants following colchicine treatment of microspore-derived embryos of oilseed rape (Brassica napus L.). Plant Cell Tissue Organ Cult. 2012, 108, 251–256. [Google Scholar] [CrossRef]
- Keller, W.A.; Armstrong, K.C. High frequency production of microspore derived plants from Brassica napus anther cultures. Z. Pflanzenzuchtg. 1978, 80, 100–108. [Google Scholar]
- Chen, J.L.; Beversdorf, W.D. Production of spontaneous diploid lines from isolated microspores following cryopreservation in spring rapeseed (Brassica napus L.). Plant Breed. 1992, 108, 324–327. [Google Scholar] [CrossRef]
- Hiramatsu, M.; Odahara, K.; Matsue, Y. A survey of microspore embryogenesis in leaf mustard (Brassica juncea). Acta Hort. 1995, 392, 139–145. [Google Scholar] [CrossRef]
- Lionneton, E.; Beuret, W.; Delaitre, C.; Ochatt, S.; Rancillae, M. Improved microspore culture and doubled haploid plant regeneration in the brown condiment mustard (Brassica juncea). Plant Cell Rep. 2001, 20, 126–130. [Google Scholar] [CrossRef]
- Alexander, M.P. Differential staining of aborted and non-aborted pollen. Stain Technol. 1969, 44, 117–122. [Google Scholar] [CrossRef] [PubMed]
- Murashige, T.; Skoog, F. A revised medium for rapid growth and bio-assays with tobacco tissue cultures. Physiol. Plant. 1962, 15, 473–497. [Google Scholar] [CrossRef]
- Schwarzacher, T. Preparation and Fluorescent Analysis of Plant Metaphase Chromosomes. In Plant Cell Division. Methods in Molecular Biology; Caillaud, M.C., Ed.; Humana Press: New York, NY, USA, 2016; Volume 1370, pp. 87–103. [Google Scholar] [CrossRef]

| Variety | Mean Embryo Numbers Per Petri Dish, pcs | Mean Callus Number Per Petri Dish, pcs |
|---|---|---|
| Ronde witte roodkop herfst | 5.0 a * | 1.3 a |
| Snow ball | 3.0 a | 3.0 b |
| York Globe | 3.3 a | 2.5 b |
| Roots | 20.7 b | 0 c |
| pH Level | AC Presence/Absence in the Medium | Mean Embryo Numbers Per Petri Dish, pcs. |
|---|---|---|
| 5.8 | + | 17.2 a |
| − | 15.6 a | |
| 6.2 | + | 23.0 b |
| − | 16.3 a | |
| 6.6 | + | 53.4 c |
| − | 25.6 ab |
| Variety | pH Level * | Flower Buds Pre-Treated at 10 °C for 2 Days | Mean Embryo Numbers Per Petri Dish, pcs | Mean Callus Numbers Per Petri Dish, pcs |
|---|---|---|---|---|
| Ronde witte roodkop herfst | 6.2 | + | 8.7 a | 0 a |
| − | 2.7 b | 4.1 b | ||
| Snow ball | 6.2 | + | 7.9 ad | 5.6 b |
| − | 0 c | 31.2 c | ||
| York Globe | 6.6 | + | 5.7 d | 1.5 d |
| − | 1.2 e | 20.1 e | ||
| Roots | 6.6 | + | 65.7 f | 0 a |
| − | 50.8 g | 0 a |
| Number of Observed Plantlets, psc | Diploid Plant, % | Haploid Plant,% | |
|---|---|---|---|
| Plantlets obtained directly from primary embryos | 215 | 40.0 | 60.0 |
| Plantlets obtained as the result of germination of secondary embryos | 203 | 71.9 | 28.1 |
| VIR Catalog Number | Name | Country |
|---|---|---|
| k-995 | Ronde witte roodkop herfst | Netherlands |
| k-1255 | Snow ball | India |
| k-1281 | York Globe | Australia |
| k-1380 | Roots | USA |
© 2020 by the authors. Licensee MDPI, Basel, Switzerland. This article is an open access article distributed under the terms and conditions of the Creative Commons Attribution (CC BY) license (http://creativecommons.org/licenses/by/4.0/).
Share and Cite
Shumilina, D.; Kornyukhin, D.; Domblides, E.; Soldatenko, A.; Artemyeva, A. Effects of Genotype and Culture Conditions on Microspore Embryogenesis and Plant Regeneration in Brassica Rapa ssp. Rapa L. Plants 2020, 9, 278. https://doi.org/10.3390/plants9020278
Shumilina D, Kornyukhin D, Domblides E, Soldatenko A, Artemyeva A. Effects of Genotype and Culture Conditions on Microspore Embryogenesis and Plant Regeneration in Brassica Rapa ssp. Rapa L. Plants. 2020; 9(2):278. https://doi.org/10.3390/plants9020278
Chicago/Turabian StyleShumilina, Daria, Dmitry Kornyukhin, Elena Domblides, Alexey Soldatenko, and Anna Artemyeva. 2020. "Effects of Genotype and Culture Conditions on Microspore Embryogenesis and Plant Regeneration in Brassica Rapa ssp. Rapa L." Plants 9, no. 2: 278. https://doi.org/10.3390/plants9020278
APA StyleShumilina, D., Kornyukhin, D., Domblides, E., Soldatenko, A., & Artemyeva, A. (2020). Effects of Genotype and Culture Conditions on Microspore Embryogenesis and Plant Regeneration in Brassica Rapa ssp. Rapa L. Plants, 9(2), 278. https://doi.org/10.3390/plants9020278







